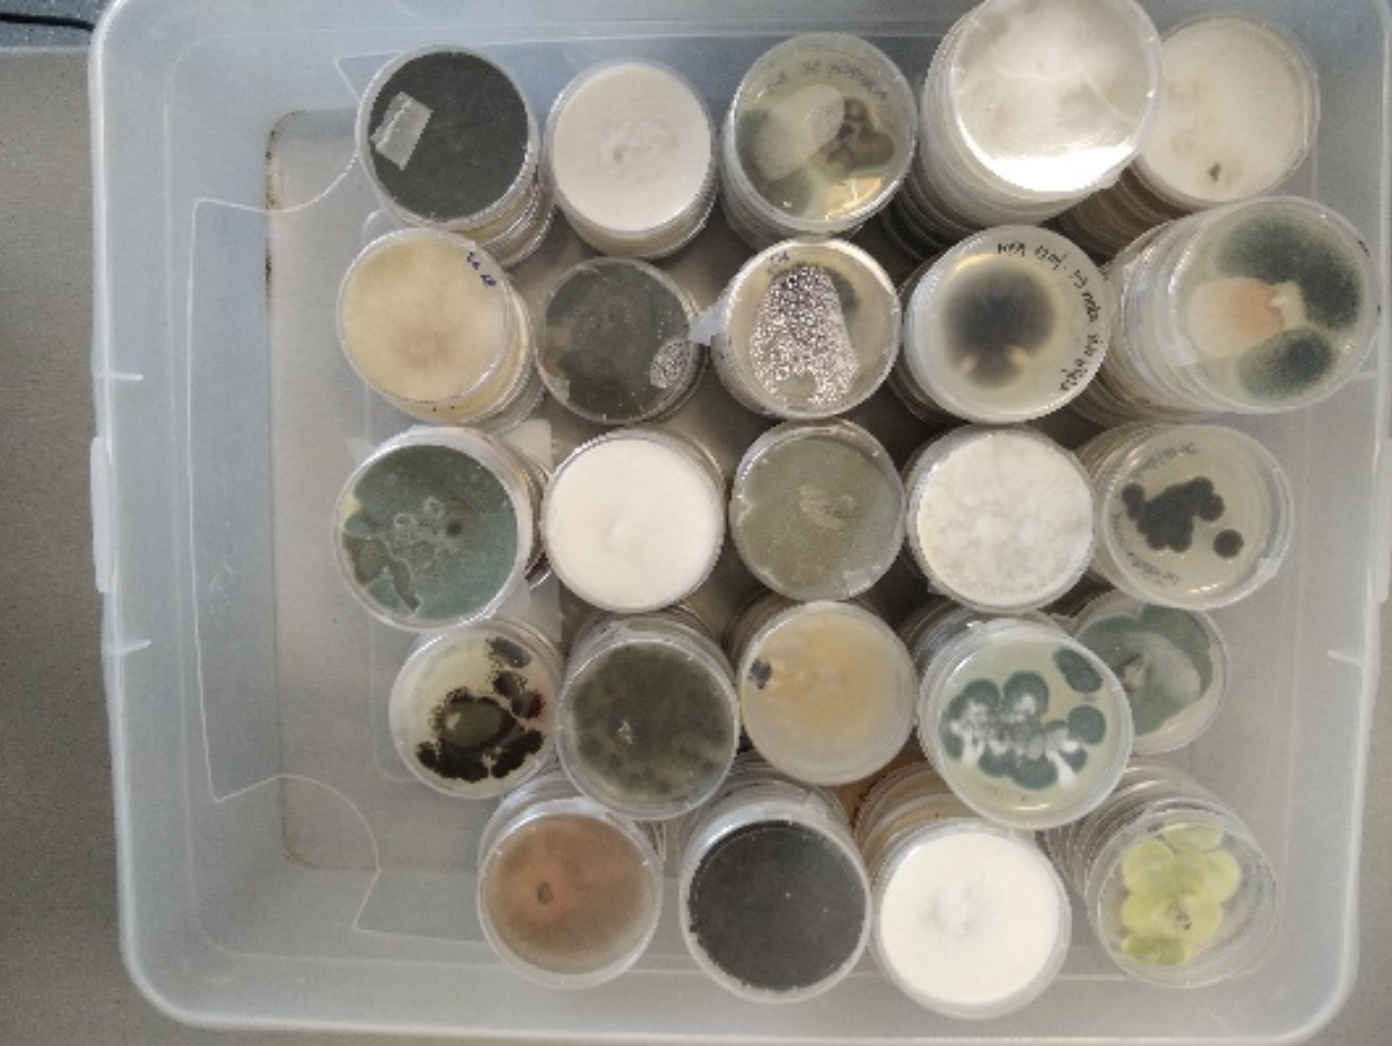

Znanstveno istraživački modularni pilot projekt:
KultBaMikroo – Zaštita zadarske kulturne baštine od negativnog utjecaja mikroorganizama
Predavanje/radionica na Međužupanijskom stručnom vijeću kemijskih tehnologa s područja Dalmacije, Zadar
U Prirodoslovno-grafičkoj školi u Zadru dana 11. 6. 2022 godine održalo se 2. Međužupanijsko stručno vijeće kemijskih tehnologa s područja Dalmacije. Sudjelovali su djelatnici stručnog obrazovnog sektora Geologija, rudarstvo, nafta i kemijska tehnologija – podsektor kemijska tehnologija za Zadarsku i Splitsko-dalmatinsku županiju. Dr. sc. Jelena Lončar s Odjela za ekologiju, agronomiju i akvakulturu Sveučilišta u Zadru održala je predavanje i radionicu na temu “Zaštita zadarske kulturne baštine od negativnog utjecaja mikroorganizama u sklopu projekta KultBaMikroo”, financiranog od strane Sveučilišta u Zadru (IP.01.2021.12). Sudionici su se upoznali s tehnikama uzorkovanja gljivica s raznih supstrata, kao i s tehnikama kultivacije gljivica, priprave čistih kultura te metodama morfološke determinacije celulolitičkih gljivica.